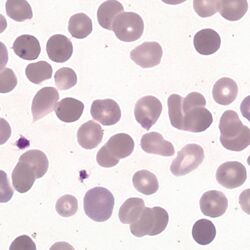

Spherocytes
From haematologyetc.co.uk
Derivation: From the Greek [sphere]
Appearance
The typical spherocyte is dense and round, lacking central pallor and appearing smaller than normal erythrocytes. They do not generally appear irregular, but may do so if other pathology is present (e.g. post-splenectomy). However, since the spherical form is the end of a what is often a progressive process, cells of intermediate appearance between biconcave disc and true sphere may be found.
Images Spherocytes are characterised by the absence of central pallor in a cell that has a uniform cell outline and uniform haemoglobin distribution. Since the cell often arises in the setting of red cell damage it is not unusual to have some irregularity of shape or crenation, but the typical regular forms are shown here. The normal cells present will draw attention to the slightly reduced size of the spherocyte, and there will often be forms with features that are intermediate between spherocyte and normal cell. A marrow response indicated by polychromatic cells is an expected finding. Look also for features that might indicate the cause e.g. fragmentation.
Significance
While not present on normal blood films, occasional spherocytes may derive from many causes. The significance of spherocytes must therefore always be considered within the context of their frequency, and of the presence or absence of other disease features (see causes). Where spherocytes are very frequent autoimmune haemolysis or hereditary spherocytosis should be considered.
Pitfalls
Be sure to examine the correct part of the blood film. If the film is viewed close to the tail where cells are widely separated, normal erythrocytes lack central pallor and may be mistaken for spherocytes. Where membrane and cell contents are lost together (e.g. in red cell fragmentation disorders), some erythrocytes may form spherocytes or microspherocytes but these should be viewed as part of the fragmentation process. Similarly, irregularly contracted cells are formed when haemoglobin is unstable or damaged and these should be distinguished by their irregular outline and often irregularly condensed haemoglobin. Finally, spiculated cells at the end of their life can become dense (sphero-acanthocytes or sphero-echinocytes), these should be distinguished from true spherocytes.
Causes
| Inherited defects of membrane proteins (hereditary spherocytosis) |
|---|
| Instability of the lipid bilayer (band 3 deficiency) |
| Reduced cytoskeletal density (defects of spectrin, ankyrin, or Band 4.2) |
| Immune damage to erythrocyte membrane (immune haemolytic anaemias) |
| Autoimmune haemolytic anaemia: spherocytes are most obvious in warm autoimmune haemolysis, but may also be seen in cold haemagglutinins or drug-induced haemolysis |
| Alloimmune haemolysis including immediate and delayed transfusion reactions and haemolytic disease of the newborn. |
| Physical or chemical damage to the erythrocyte membrane (non-immune haemolytic anaemias) |
| Microangiopathic haemolytic anaemia |
| Physical e.g. mechanical valve |
| Toxins e.g. Clostridium perfringens |
| Heat e.g. burns |
Clinical Examples: spherocytes
Clinical Image 1 There are several fully formed spherocytes and other cells retaining some central pallor. Note also the increased number of larger polychromatic cells indicating a bone marrow response with release of newly formed erythrocytes. Clinical condition: autoimmune haemolysis.
Clinical Image 2 A more marked appearance than the previous example with the majority of cells showing spherocytic form or evidence of damage. One polychromatic cell is present and a further cell shows the presence of a Howell Jolly body. This is hereditary spherocytosis. The patient has had a splenectomy as treatment for the condition and there is some irregularity of cells as is often seen in hyposplenic states. Clinical condition hereditary spherocytosis post-splenectomy.
Pathobiology of spherocytes
The underlying defect is the progressive loss of surface membrane without a similar loss of volume. This causes the erythrocyte shape to change from one with a very high surface area to volume ratio (the biconcave disc) to a cell with minimum surface area to volume ratio (a sphere). The flattened appearance in 2-D is a disc lacking central pallor. Damage to the erythrocyte membrane may arise from different mechanisms, but the final appearance is the same – the cause may in some cases be apparent because of associated changes to other cells.